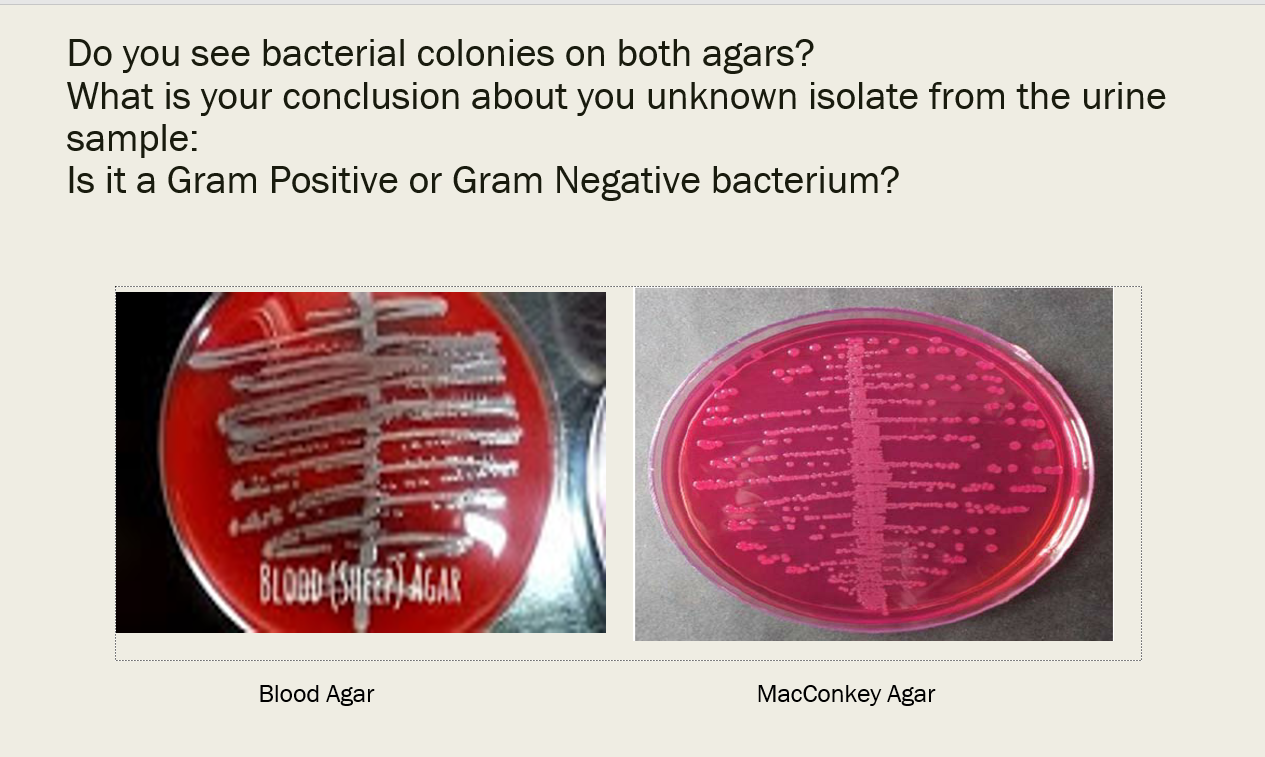
Solved Urine Culture To Diagnose Uti Caused By Gram Chegg Com

Your Urine culture gram negative rods images are available in this site. Urine culture gram negative rods are a topic that is being searched for and liked by netizens now. You can Find and Download the Urine culture gram negative rods files here. Download all royalty-free photos and vectors.
If you’re searching for urine culture gram negative rods images information connected with to the urine culture gram negative rods topic, you have come to the ideal blog. Our site always provides you with hints for seeking the highest quality video and image content, please kindly surf and locate more informative video content and images that match your interests.
Urine Culture Gram Negative Rods. Gram Negative Rod Infections. Less 10000 cfuml gram negative rods on urine culture. Gram-Negative Bacilli Introduction to Gram-Negative Bacilli Gram-negative bacilli are responsible for numerous diseases. Schaalii UTI Gram-positive bacteria are often evident by direct microscopy and yet typical aerobic urine culture often produces a negative result 266 268.
 A Gram Stain Of Uncentrifuged Urine Shows Gram Positive Rods And Download Scientific Diagram From researchgate.net
A Gram Stain Of Uncentrifuged Urine Shows Gram Positive Rods And Download Scientific Diagram From researchgate.net
Indicate either Clean Catch or Cath. In typical cases a urine culture is not necessary. Gram-Negative Rods For practical purposes it is not possible to distinguish gram-negative rods based on the morphology observed with the Gram stain. URINE CULTURE ApprovedBy. In men unlike in women a urine culture growing more than 1000 CFU of a pathogen per mL of urine is the best sign of a urinary tract infection with a sensitivity and specificity of 97 percent. Symptoms urge to pee constantly blood in urine and painful.
Lactose fermentation on Mac.
In clinical cases of A. I had also taken two macrobid before the. URINE CULTURE INTERPRETIVE GUIDE IMPORTANT. See individual Microgen GN ID procedure for further instructions. Less 10000 cfuml gram negative rods on urine culture. No this urine culture is not eligible for use in an NHSN UTI determination.
 Source: aafp.org
Source: aafp.org
Other oxidase negative gram negative rods may be identified using the Microgen GN ID system. Gram-negative bacteria cause infections including pneumonia bloodstream infections wound or surgical site infections and meningitis in healthcare settings. Diagnosis is based on analysis and culture of urine. Test PRELIM RPT SOURCE. 822016 640 AM In Range Microbiology results Out of F CFIJmL Gram Negative Rods Id and Sensitivity to Fallow.
 Source: universe84a.com
Source: universe84a.com
Diagnosis is based on analysis and culture of urine. Coli Urea positive Gram negative bacteria UPGNB Klebsiella Enterobacter Pseudomonas in a decreasing order. Coli with Gram-positive Staphylococcus Streptococcus and Enterococcus infections and mixed-bacterial infections reported less frequently1011 Familiarity with the most common urinary pathogens along with bacterial morphology identified by urine sediment. Test PRELIM RPT SOURCE. Aerobic Gram-Negative Rods Flowchart Gram Stain Gram Negative Rods or Gram Negative Coccobacilli.
Diagnosis is based on analysis and culture of urine. Gram-negative rods GNR are the most common pathogens associated with urinary tract infections UTI. Schaalii UTI Gram-positive bacteria are often evident by direct microscopy and yet typical aerobic urine culture often produces a negative result 266 268. I had also taken two macrobid before the. The resistance of these gram-negative rods to various antibiotics is increasing with time.
 Source: slideserve.com
Source: slideserve.com
CULTURE REPORT CFUML colony forming units per milliliter of urine INTERPRETATION. Current management guidelines recommend empirical therapy for acute uncomplicated lower UTIs in young women 23. Io CATH COLONY COUNT 822016 640 AM RESULT. Symptoms urge to pee constantly blood in urine and painful. URINE CULTURE INTERPRETIVE GUIDE IMPORTANT.
 Source: basicmedicalkey.com
Source: basicmedicalkey.com
Coli Urea positive Gram negative bacteria UPGNB Klebsiella Enterobacter Pseudomonas in a decreasing order. URINE CULTURE INTERPRETIVE GUIDE IMPORTANT. See individual Microgen GN ID procedure for further instructions. Gram-negative infections include those caused by Klebsiella Acinetobacter Pseudomonas aeruginosa and E. When a report says rare gram -negative rod it does not mean an unusual bacterium but that it was present in low numbers.
 Source: researchgate.net
Source: researchgate.net
Gram-Negative Rods For practical purposes it is not possible to distinguish gram-negative rods based on the morphology observed with the Gram stain. Gram-negative rods GNR are the most common pathogens associated with urinary tract infections UTI. Coli with Gram-positive Staphylococcus Streptococcus and Enterococcus infections and mixed-bacterial infections reported less frequently1011 Familiarity with the most common urinary pathogens along with bacterial morphology identified by urine sediment. Gram Negative Rod Infections. Other oxidase negative gram negative rods may be identified using the Microgen GN ID system.
 Source: quizlet.com
Source: quizlet.com
Gram Positive Cocci Anaerobes Streptococci Gram Negative Bacilli Staphylococci Gram Negative Coccobacilli Atypicals Bacteria Clostridium difficile Mycoplasma pneumoniae Chlamydophila spp Legionella pneumophila Amoxicillin-clavulanate Cefoxitin. When evaluating patients with a suspected urinary tract infection and when gram-negative rods are found in the urine one should define if the patient needs to receive outpatient antibiotic therapy or require inpatient intravenous antibiotic therapy. - Lactose-positive gram negative rods may suggest Enterobacteriaceae such as E. Schallii was isolated using anaerobic blood culture techniques were documented only after culture conditions were altered eventually leading to the identification of A. Symptoms urge to pee constantly blood in urine and painful.
 Source: researchgate.net
Source: researchgate.net
Cases of apparent urosepsis where A. Some are commensal organisms present among normal intestinal flora. I had also taken two macrobid before the. The resistance of these gram-negative rods to various antibiotics is increasing with time. In order to provide appropriate identification and susceptibility results an accurate source must be recorded on all urine culture orders.
 Source: basicmedicalkey.com
Source: basicmedicalkey.com
Indicate either Clean Catch or Cath. CULTURE REPORT CFUML colony forming units per milliliter of urine INTERPRETATION. The resistance of these gram-negative rods to various antibiotics is increasing with time. Of Gram-negative bacteria is cultured from most UTIs typically E. - Branching Gram positive rods modified acid fast stain positive may suggest Nocardia or Streptomyces species.
 Source: labtestsonline.org.au
Source: labtestsonline.org.au
Indicate either Clean Catch or Cath. The order of Gram negative frequencies was E. Coli as well as many other less common bacteria. Io CATH COLONY COUNT 822016 640 AM RESULT. I had also taken two macrobid before the.
 Source: researchgate.net
Source: researchgate.net
Cases of apparent urosepsis where A. When evaluating patients with a suspected urinary tract infection and when gram-negative rods are found in the urine one should define if the patient needs to receive outpatient antibiotic therapy or require inpatient intravenous antibiotic therapy. Growth on MacConkey Agar. Gram Positive Cocci Anaerobes Streptococci Gram Negative Bacilli Staphylococci Gram Negative Coccobacilli Atypicals Bacteria Clostridium difficile Mycoplasma pneumoniae Chlamydophila spp Legionella pneumophila Amoxicillin-clavulanate Cefoxitin. Gram-Negative Rods For practical purposes it is not possible to distinguish gram-negative rods based on the morphology observed with the Gram stain.
 Source: universe84a.com
Source: universe84a.com
Less 10000 cfuml gram negative rods on urine culture. Cases of apparent urosepsis where A. Less 10000 cfuml gram negative rods on urine culture. The study aimed to determine the pattern of resistance to antibiotics in GNR causing urinary tract infection in adults. In clinical cases of A.
 Source: researchgate.net
Source: researchgate.net
Oxidase positive gram negative rods should be sent to Quest on a blood agar slant for ID and sensitivities. Of Gram-negative bacteria is cultured from most UTIs typically E. Growth on MacConkey Agar. The order of Gram negative frequencies was E. Others such as gram-negative rods represent groups of similar bacteria and will require additional testing to determine exactly which type of bacteria is present.
 Source: slideplayer.com
Source: slideplayer.com
- Lactose-positive gram negative rods may suggest Enterobacteriaceae such as E. Cases of apparent urosepsis where A. What does it mean bacteria in. I had also taken two macrobid before the. The study aimed to determine the pattern of resistance to antibiotics in GNR causing urinary tract infection in adults.
 Source: researchgate.net
Source: researchgate.net
Lactose fermentation on Mac. Symptoms urge to pee constantly blood in urine and painful. Test PRELIM RPT SOURCE. Io CATH COLONY COUNT 822016 640 AM RESULT. Other oxidase negative gram negative rods may be identified using the Microgen GN ID system.
 Source: dreamstime.com
Source: dreamstime.com
The next day urine and blood cultures show Gram-negative rods After 72 hours of hydration and intravenous antibiotics your patient is still febrile and repeat urine examination is still notable for pyuria and bacteriuria You are concerned about urinary obstruction intrarenalperinephric abscess infection with resistant organism. Of Gram-negative bacteria is cultured from most UTIs typically E. Lactose fermentation on Mac. Coli as well as many other less common bacteria. The resistance of these gram-negative rods to various antibiotics is increasing with time.
 Source: researchgate.net
Source: researchgate.net
The next day urine and blood cultures show Gram-negative rods After 72 hours of hydration and intravenous antibiotics your patient is still febrile and repeat urine examination is still notable for pyuria and bacteriuria You are concerned about urinary obstruction intrarenalperinephric abscess infection with resistant organism. Coli Klebsiella or Enterobacter spp. Other oxidase negative gram negative rods may be identified using the Microgen GN ID system. Gram-negative rods GNR are the most common pathogens associated with urinary tract infections UTI. Gram-Negative Rods For practical purposes it is not possible to distinguish gram-negative rods based on the morphology observed with the Gram stain.
 Source: researchgate.net
Source: researchgate.net
The next day urine and blood cultures show Gram-negative rods After 72 hours of hydration and intravenous antibiotics your patient is still febrile and repeat urine examination is still notable for pyuria and bacteriuria You are concerned about urinary obstruction intrarenalperinephric abscess infection with resistant organism. Symptoms urge to pee constantly blood in urine and painful. In order to provide appropriate identification and susceptibility results an accurate source must be recorded on all urine culture orders. No this urine culture is not eligible for use in an NHSN UTI determination. 822016 640 AM In Range Microbiology results Out of F CFIJmL Gram Negative Rods Id and Sensitivity to Fallow.
This site is an open community for users to submit their favorite wallpapers on the internet, all images or pictures in this website are for personal wallpaper use only, it is stricly prohibited to use this wallpaper for commercial purposes, if you are the author and find this image is shared without your permission, please kindly raise a DMCA report to Us.
If you find this site convienient, please support us by sharing this posts to your preference social media accounts like Facebook, Instagram and so on or you can also bookmark this blog page with the title urine culture gram negative rods by using Ctrl + D for devices a laptop with a Windows operating system or Command + D for laptops with an Apple operating system. If you use a smartphone, you can also use the drawer menu of the browser you are using. Whether it’s a Windows, Mac, iOS or Android operating system, you will still be able to bookmark this website.






